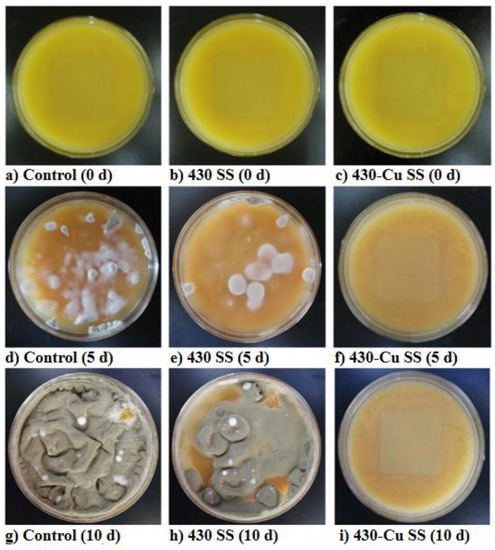

マイストア
変更
お店で受け取る
(送料無料)
配送する
納期目安:
2025.10.09 15:15頃のお届け予定です。
決済方法が、クレジット、代金引換の場合に限ります。その他の決済方法の場合はこちらをご確認ください。
※土・日・祝日の注文の場合や在庫状況によって、商品のお届けにお時間をいただく場合がございます。
アップル アップル(Apple) MF0V4J/A Apple Watch Ultra 3(GPS + Cellularの詳細情報
アップル(Apple) MF0V4J/A Apple Watch Ultra 3(GPS + Cellular。公式】APPLE WATCH(R) ストラップ・42MM/44MM/45MM|コーチ。Vue 撥水レザーレースアップスニーカー 【VO81693H】 – EIZO WEB。◇ジャガードでロゴがデザインされた、シンプルかつスポーティなデザインの使いやすいカートバッグです。保冷裏地仕様で夏に最適なアイテムです。- ブランド: descente- カラー: ホワイト- デザイン: トートバッグ- ストラップ: ブラックのハンドル- ロゴ: デザインにロゴ入り- 素材: 合成素材■サイズ(W×D×H):約23×22×15cm■メーカー型番: DQCXJA45■JAN: 4992661227222ご覧いただきありがとうございます。。JORDAN BRAND JORDAN CP3.X AE RIVER ROCK/BLACK-METALLIC。Xtreye SQ1 ゴルフ用距離計 ケース付き。HUAWEI WATCH GT 5 Pro 本体と付属品
ベストセラーランキングです
近くの売り場の商品
カスタマーレビュー
オススメ度 4.1点
現在、3201件のレビューが投稿されています。